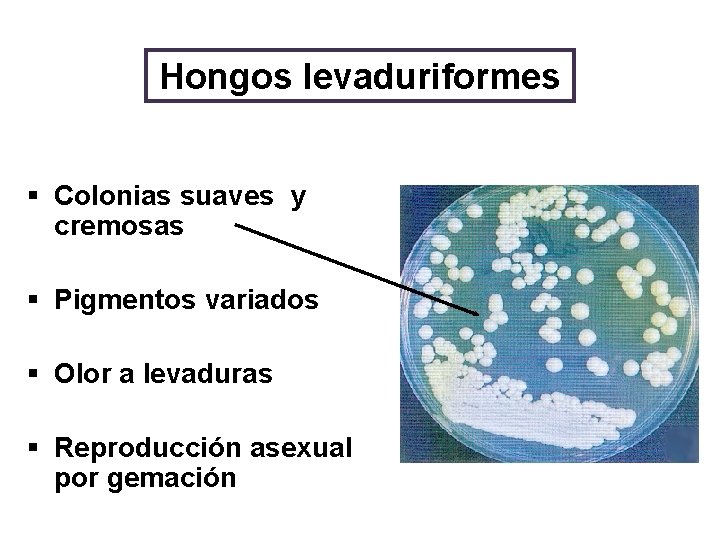
Hongos levaduriformes § Colonias suaves y cremosas § Pigmentos variados § Olor a levaduras

Tema III Micologa Mdica Generalidades de Micologa Colectivo

- Slides: 46
Tema III Micología Médica Generalidades de Micología Colectivo de autores Microbiología y Parasitología
Objetivos 1. Argumentar la importancia de los hongos. 2. Explicar las diferencias elementales entre hongos filamentosos y levaduriformes. 3. Mencionar las características que identifican a los hongos de otros agentes. 4. Relacionar como se clasifican las enfermedades producidas por hongos. 5. Explicar la respuesta inmune en infecciones micóticas.
Contenido v Micología Médica. v Importancia de los hongos. v Clasificación. v Características generales. v Clasificación de las micosis. v Respuesta inmune de las micosis
Bibliografía: ü Microbiología y Parasitología Médicas. Llop, Valdés. Dapena, Zuazo. Tomo I. Capítulo 41. Bibliografía complementaria. ü Jawetz y col. Microbiología médica, 14. Ed. 2006. ü A. Bonifaz. Micología médica básica. 1991. ü Gatti-Cardama. Dermatología. 2003. ü Colectivo de autores. Dermatología. 2008. ISCM-H. CD asignatura
¿Qué es la Micología? Del griego mykes (hongo) y logos, tratado Ciencia que se encarga del estudio de los hongos
Antecedentes de la Micología. • 1677 Hooke comienza el estudio de los Hongos construye lentes. • 1729 Michell describe el género Aspergillus. • Siglo XIX se realizan progresos en la micología. • Actualmente existen 50 000 a 100 000 especies aceptadas. • Alrededor 200 son patógenos al hombre y animales.
IMPORTANCIA DE LOS HONGOS Ornamentales Alimentación humana Enfermedades en plantas, animales y el hombre Desintegración de la materia orgánica Procesos biotecnológicos Procesos industriales
¿QUE ES UN HONGO?
Características generales - Eucariotas, aerobios, inmóviles, heterótrofos. - Pared celular constituida de polisacárido (90% del peso seco). -Reproducción sexual y asexual* -Algunos poseen cápsula de polisacáridos. -Unicelulares (levaduras) o pluricelulares (filamentosos)
Morfología - Hongos filamentosos - Hongos levaduriformes - Hongos dimorfos
Hongos filamentosos El elemento primario es la hifa o filamento, una estructura cilíndrica. Hifas septadas Hifas aseptadas
Hifas no septadas: Formadas por una masa multinuclear de citoplasma continuo. Hifas septadas: Tienen las células separadas por paredes transversales. Los tabiques tienen agujeros que permiten el flujo del material citoplasmático entre las células. Hifa no septada Hifa septada
Formas de las hifas Espirales Raquetas Nodulares Candelabros fávico Pectinadas
Hongos filamentosos Conjunto de hifas Micelio Aéreo o reproductivo Crece en la superficie y en el se encuentran las esporas. Función reproductora. Vegetativo o nutritivo Se introduce en el medio de cultivo. Función nutritiva.
Hongos filamentosos Cultivo ØMedio Agar Sabouraud glucosa ØTemperatura ambiente 7 – 14 días
Hongos filamentosos Colonias Lanosas Se desarrollan en el micelio aéreo y según género y especie tendrán diferente forma y color. Aterciopeladas Pulverulentas
Hongos levaduriformes - Células ovales, redondeadas (blastosporas o blastoconidias) - Se reproducen por gemación. -Pueden formar un pseudomicelio
Hongos levaduriformes Cultivo Ø Medio Agar Sabouraud glucosa Ø 37ºC Ø 2 – 3 días
Hongos levaduriformes § Colonias suaves y cremosas § Pigmentos variados § Olor a levaduras § Reproducción asexual por gemación
Hongos dimorfos Fase filamentosa Fase levaduriforme *Depende de factores como temperatura y nutrientes.
Hongos dimorfos • Forma filamentosa: En la naturaleza Medios pobres en nutrientes Laboratorio a 25°C Histoplasma capsulatum 25 °C • Forma levaduriforme: En los tejidos Medios ricos en nutrientes Laboratorio a 37°C 37 °C Micro y macroconidias Tejidos
Reproducción de los hongos ü Los hongos se reproducen sexual y asexualmente. ü La reproducción asexual es la mas importante desde el punto de vista médico, ya que la mayoría de los hongos patógenos para el hombre se reproducen asexualmente, las esporas asexuales se denominan conidias. ü Las esporas de los hongos filamentosos nacen del micelio aéreo y sus características se emplean para la identificación de los mismos.
Clasificación de los hongos (Whittaker, 1969) Hongos perfectos Hongos imperfectos Poseen reproducción sexual y asexual. Poseen reproducción asexual solamente. Clases: • Zygomycetes o Phycomycetes. (Mucor, Rhizopus) • Basidiomycetes. • Ascomycetes. • Deuteromycetes: La mayoría de los patógenos al hombre
Reproducción Esporas Asexuales (conidias) Sexuales • Zigosporas • Ascosporas • Basidiosporas • Talosporas Artrosporas Blastosporas Clamidosporas Se producen por meiosis • Conidias Macroconidias Microconidias • Esporangiosporas o endosporas
Reproducción Por conidias o esporas asexuales Microconidias Macroconidias Pequeñas, unicelulares, redondas o piriformes Grandes, fusiformes, septadas o multiseptadas
Producidas por hifas especializadas (conidióforos), por estrangulamientos sucesivos del punto de unión.
Reproducción Por conidias o esporas asexuales Blastosporas Célula redonda u oval que se reproduce por gemación
Reproducción Por conidias o esporas asexuales Artrosporas Hifa septada se fragmenta en células individuales
Reproducción Por conidias o esporas asexuales Clamidosporas Las células en la hifa se agrandan y forman paredes gruesas. Resistentes a condiciones ambientales desfavorables. Germinan cuando las condiciones mejoren.
Reproducción Por conidias o esporas asexuales Esporangiosporas Se forman en un saco (esporangio), sostenido por una hifa llamada “esporangióforo”
Reproducción Por esporas sexuales Se producen por meiosis y de acuerdo a su origen pueden ser: Zigosporas Ascosporas Basidiosporas
Reproducción Por esporas sexuales Zigosporas: Fusión de la punta de dos hifas. Desarrollan esporas grandes de paredes gruesas.
Reproducción Por esporas sexuales Ascosporas: Dentro de una célula especializada llamada asca se forman de 4 a 8 esporas.
Reproducción Por esporas sexuales Basidioesporas: En la superficie de una célula especializada llamada basidio se forman 4 esporas. Posee estructuras llamadas basidios. Cada basidio produce estructuras llamadas Basidiosporos.
• Alergia: Sensibilización a antígenos específicos de los hongos • Micotoxicosis: Ingestión de toxinas elaboradas por los hongos • Micetismo: Ingestión de hongos venenosos o alucinógenos • Micosis: Infecciones causadas por la presencia del hongo en los tejidos del hospedero
Formas de adquisición de las micosis Endógena Exógena § El hongo forma parte de la microbiota normal § Inhalación § Requiere de factores predisponentes § Implantación traumática (Candidiosis) (Histoplasma) (Cromomicosis) § Contacto (Dermatofitos)
Micosis: Clasificación 1. Superficiales Causadas por hongos de muy baja patogenicidad, que sólo atacan las capas más superficiales de la piel y sus apéndices • Pitiriasis versicolor • Piedra blanca • Piedra negra • Tiña negra
Micosis: Clasificación 2. Cutáneas Invaden todos los tejidos queratinizados (piel, pelos y uñas) • Dermatofitosis • Candidiasis de piel y uñas
Micosis: Clasificación 3. Subcutáneas Infecciones que involucran piel, tejido celular subcutáneo y en ocasiones huesos • Esporotricosis • Cromomicosis
Micosis: Clasificación 4. Sistémicas o profundas Afectan órganos internos Patógenos verdaderos Patógenos oportunistas • Histoplasmosis • Candidiosis • Coccidioidomicosis • Criptococosis • Blastomicosis • Aspergilosis • Paracoccidioidomicosis • Mucormicosis
Principales mecanismos de los hongos para producir la infección Mecanismos Tipos de micosis Contacto directo Micosis cutáneas Traumatismos cutáneos Micosis subcutáneas Inhalación Micosis sistémicas Yatrogenia Micosis oportunistas Ejemplos Hombre al hombre: Trichophyton tonsurans Animal al hombre: Microsporum canis Suelo al hombre: Microsporum gypseum Fonsecaea pedrosoi Madurella grisea Histoplasma capsulatum Coccidioides immitis Aspergillus, Candida, Mucor
Principales factores de virulencia de los hongos patógenos Factores de virulencia Ejemplos Dimorfismo H. capsulatum, C. immitis, C. albicans Proteasas C. albicans Adhesinas C. albicans Fenoloxidasa C. neoformans Elastasa A. fumigatus Melanina F. pedrosoi, C. neoformans Cápsula C. neoformans Queratinasas Dermatofitos Catalasas H. capsulatum Parasitismo intracelular H. capsulatum Abundantes microconidios A. fumigatus, H. capsulatum
RESPUESTA INMUNE EN INFECCIONES MICÓTICAS
Mecanismos inespecíficos de defensa §Barrera hística (piel y mucosas) §Fagocitosis (PMN, macrófagos y monocitos) §Células NK ü Efecto directo: lisis de la célula. ü Efecto indirecto: producción de linfoquinas que activan PMN y monocitos.
Mecanismos específicos de defensa Humorales ü Interfieren la adherencia. ü Potencian la fagocitosis (opsonización). ü Neutralizan productos importantes para la invasión tisular (proteasas, fosfolipasas). Celulares ü Inducida por linfocitos Th
Mecanismos de escape a la respuesta humoral. Los hongos pueden ser resistentes, escapar o neutralizar los efectos de los Ac. 1. Suelen ser resistentes a la lisis mediada por el C′ probablemente por el mayor grosor de su pared celular. 2. Muchos producen proteasas que degradan a las Igs. 3. Las variaciones antigénicas pueden facilitar el escape a la inmunidad mediada por Ac. 4. Producen sustancias inmunomoduladoras que inducen tolerancia inmunológica.